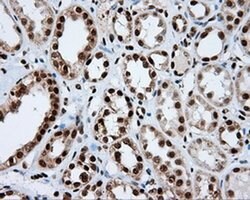
Invitrogen KIAA1609 Monoclonal Antibody (OTI12B1) 100 &mu;L; Unconjugated:Antibodies,

missing translation for 'onlineSavingsMsg'
Learn More
Learn More
Invitrogen™ KIAA1609 Monoclonal Antibody (OTI12B1)


Mouse Monoclonal Antibody
Brand: Invitrogen™ MA525070
This item is not returnable.
View return policy
Description
KIAA1609 Monoclonal Antibody for Western Blot, ICC/IF, IHC (P)
TLDC1 (TBC/LysM-Associated Domain Containing 1) is a Protein Coding gene. An important paralog of this gene is NCOA7.
Specifications
| KIAA1609 | |
| Monoclonal | |
| 1.0 mg/mL | |
| PBS with 1% BSA, 50% glycerol and 0.02% sodium azide; pH 7.3 | |
| Q6P9B6 | |
| TLDC1 | |
| Full length human recombinant protein of KIAA1609 produced in HEK293T cell. | |
| 100 μL | |
| Primary | |
| Human | |
| Antibody | |
| IgG1 |
| Immunohistochemistry (Paraffin), Western Blot, Immunocytochemistry | |
| OTI12B1 | |
| Unconjugated | |
| TLDC1 | |
| 4632415K11Rik; Kiaa1609; MEAK7; MTOR associated protein, eak-7 homolog; MTOR-associated protein MEAK7; TBC/LysM associated domain containing 1; TBC/LysM-associated domain containing 1; TBC/LysM-associated domain-containing protein 1; TLD domain containing 1; TLD domain-containing protein 1; TLDC1 | |
| Mouse | |
| Affinity Chromatography | |
| RUO | |
| 57707 | |
| -20°C, Avoid Freeze/Thaw Cycles | |
| Liquid |
Product Content Correction
Your input is important to us. Please complete this form to provide feedback related to the content on this product.
Product Title
Spot an opportunity for improvement?Share a Content Correction